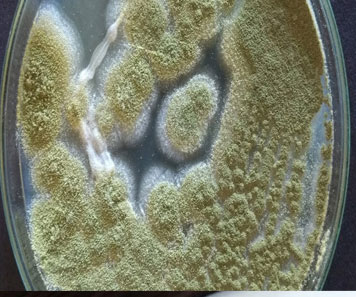
image

Skin biopsy- Shave/Excision
Skin biopsy is a procedure where a small sample of skin tissue is removed for examination under a microscope. This can help diagnose a variety of skin conditions, including skin cancers, infections, and autoimmune disorders.